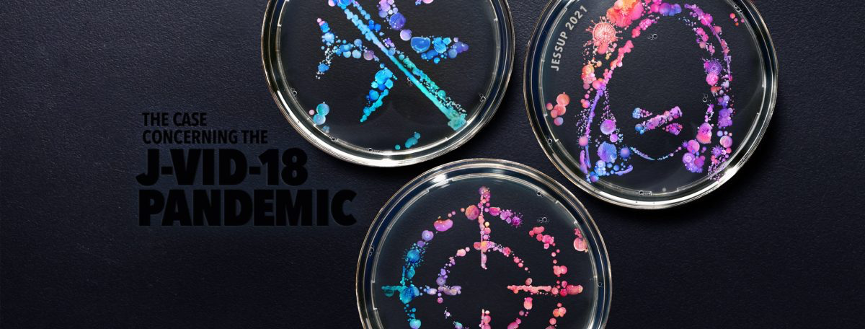

Copyright © 2024 Peking University School of Transnational Law.
2021-06-07 Views: 32
2021年4月,第62届Jessup国际法模拟法庭(Philip C. Jessup International Law Moot Court)顺利举办,北京大学国际法学院(英文简称“STL”)学子以初赛(Preliminary Rounds)中国内地第10名的成绩晋级高阶回合,并最终在本次比赛中勇夺中国内地第5名、全球百强。
Jessup国际法模拟法庭系由美国国际法学生联合会(International Law Students Association,ILSA)主办的全球规模最大、历史最悠久的专业性法律辩论赛,该赛事被誉为国际法学界的“奥林匹克竞赛”,比赛邀请国际法院(International Court of Justice)法官等业内顶尖人士进行裁判。本届赛题涉及疫情边界管控、吹哨人保护、国际法院管辖权、击落飞行器等众多国际法热点问题;受疫情影响,本届Jessup国际法模拟法庭采取了全球赛(Global Rounds)模式,全球数百只队伍通过线上进行辩论。
本届比赛主题海报
本届比赛主题海报
我院队伍自2020年10月组建,助理院长Christian Pangilinan、C.V. Starr法律讲师仇小雅和2019级学生陈靓担任赛队教练,2018级学生谢子晗、许艳花与2019级学生张健慧、王宸宇、万子珊为队员。
 全队成员合影
全队成员合影
在本届比赛初赛中,我院队伍同来自廖内大学(印度尼西亚)、莫道克大学(澳大利亚)、科威特国际法学院(科威特地区)、伦敦大学学院(英国)的参赛队伍展开激战,并以全球前168强、内地第10名的成绩晋级高阶回合(Advanced Rounds);在高阶回合中,我院遭遇新南威尔士大学(澳大利亚)、耶路撒冷希伯来大学(以色列)、西里尔与麦迪乌斯大学第一法律系(北马其顿)、国际事务研究所(埃及)等队伍,最终憾未晋级淘汰赛(Elimination Rounds)。
 初赛晋级中国内地队伍名单
初赛晋级中国内地队伍名单
经过半年多的准备、训练、竞赛,我院队伍在本届比赛中最终排名中国内地第5名、全球第82名。此外,在高阶回合中,王宸宇同学获中国内地庭辩人第3名,张健慧同学获中国内地庭辩人第9名;在初赛中,万子珊同学获中国内地庭辩人第5名、王宸宇同学获中国内地庭辩人第17名,张健慧同学获中国内地庭辩人第19名。最终,万子珊、王宸宇、张健慧同学分别获中国内地最佳辩手第5、17、19名。

 比赛留念
比赛留念
我院队伍在本次比赛中能够取得如此优异的成绩与学院的鼎力支持、教练们的悉心指导、队员们的辛勤付出以及校友的适时帮助密不可分。未来,我院将继续支持学子参与各大模拟法庭赛事,欢迎各级学生踊跃参与,在比赛中丰富阅历、提升能力。
参加Jessup是一场别样的体验,带给参赛队员们诸多收获与体会,我们期待未来有更多STL学生能够投身到Jessup中来。
谢子晗:
长达半年的备赛经历无疑是痛苦的,但是参加Jessup所带来的收获远大于痛苦。经过无数次“检索-呈现-被否定-再检索”和“回答-修改-再答-再改”的循环,拨开迷雾、解决问题的成就感和愉悦感是无与伦比的。此外,Jessup也让我收获了良师益友,与各位队友一起在307通宵奋战、苦中作乐,和教练们一起反复讨论的时光都是我在STL最美好的记忆。
许艳花:
Jessup比赛已经圆满落幕,但是关于备赛的记忆依然鲜活如昨。参赛前,我对参加模拟法庭比赛的期待是“尽力而为,享受其中”。作为法学生,有机会参加一次高水准的模拟法庭比赛,无疑是一份难忘和不可多得的经历。同时,我也预见到备赛过程会非常辛苦,毕竟是Jessup。我深知我能力有限,仍然希望在面对无穷无尽的挑战和挫折时,能够通过不断的自我提升与调整来学会从容应对。虽然,由于赛程与实习冲突,我抱憾没能参加最终的oral rounds。但是,我完整地参与了整个备赛过程,并在高强度的法律检索和庭辩训练中,获得了我最初所期望的一切,更是收获了和团队成员之间的可贵友谊。非常感谢三位教练,他们的尽职精神、对团队每一位成员的关爱和对比赛的热忱,我相信是团队能够走到最后的关键所在。比赛虽然已经结束,但是我相信这份特殊的经历,将会成为我们大家心目中难以磨灭的宝贵回忆。衷心祝愿了不起的大家在接下来的人生道路上,能够顺顺利利、如愿拥有自己梦想的一切呐!
陈靓:
Jessup是一场盛宴,我们将用长久的时间将其缅怀。我与Jessup初次相识已是五年之前,但每一年到相遇体验均会有所不同。在国法紧张刺激的生活节奏之下,能够遇到一群同样对Jessup抱有热忱的老师、同学是件幸运的事情。从去年十月到今年四月,从表面朋友到比赛战友,我们一起走过了半年的时光。我们一起探索《国际卫生条例》义务的限度、一起讨论外交庇护如何成为可能,我们也一起在国际法院管辖权的边缘疯狂试探、一起吐槽永远不好用的某国际组织官网。
过往的经历塑造了当下的我们。当Jessup成为过往经历之时,我们便融为一体、成为对方的一部分。当国法充实的生活将我们分隔开,愿我们一起走过的半年能将我们联在一起。感谢你们的陪伴。
张健慧:
Jessup是一场不容错过的旅程,她迷样的魅力只能亲身经历才能体会。从一开始的懵懵懂懂,对赛题、赛制、国际公法等充满好奇;到中间磕磕绊绊,终日埋头在看不完的案例和学者著作之中,竟让十点上床的我习惯了熬夜。靠着这个额外获得的技能加点,还推动我通过了法考。之后团队几次通宵达旦的长谈,让我们逐渐接受并熟悉App和Ran两国的爱恨情仇,他们的主张既独立而又相互衔接,在人权和主权之间交织。最宝贵的就是团队在大大小小的讨论会中不端碰撞观点,越来越默契,收获了宝贵的友谊,相互支持前进。真心希望更多人加入Jessup大家庭,在学业之外,不如Jessup。
万子珊:
杰赛普于我而言无疑是一段特别而珍贵的回忆,至今想来仍五味杂陈。
参赛过程中,我经历的最困难时段在初始阶段,的确完美印证了“开头难”这句话。彼时修习美国法一年多的我,已较为熟悉了美国法构造完备,功能齐全,覆盖面广的案例检索平台,并对美国法体系和各部内容都有了一定认识,在接到一项案件时尚能做到淡然有序处理。但杰赛普案件涉及的是国际法,国际法院案例、联合国宪章及各类文件、各类公约、法律解释惯例法规定等大量需要快速掌握的材料,散见于网络各处,学者评注等重要二手材料也散见于各个网站,集中性不高。再加之对国际法内容本身的陌生,我在初始阶段感受到前所未有的迷茫甚至自我怀疑,常常终日浏览大量体量庞大的文件,却无法对法律问题快速定位。但经过教练和老师的耐心指导和漫长的阅读,我和队友们终于各自逐渐明确了法律争议,熟悉了在各个网站搜罗材料,速读大部头的文件。又由于赛制的原因,阅读写作主要是单打独斗式的体验,遭遇一个又一个障碍时的确是很孤独且痛苦的。但也正因为这种痛苦,让我得以感受极速的个人成长,并在问题解决中获得了莫大的满足感。
书状提交后,我们便进入到体验截然不同的庭辩训练中。得益于无比耐心认真的指导老师和教练,我们维持了高频不间断的训练,现在想来,过年期间,在全家热闹的氛围中还仿佛处在另一个时空般坚持训练的日子,的确十分难忘。庭辩训练极其重要,在法官的不断盘问和与队友的讨论中,我们被推动着去不断重新审视自己的论点论据,无数次对自己的底稿大改特改。与法官和对手不断来回反复交流的过程,尽管听来有些压力,但对我而言其实十分有趣,是一种立足于扎实法律依据上的临机处理,像是一场有来有回的球赛。
当然,印象最深刻的还是最终的比赛过程。穿梭在备赛室、打印店和比赛室,在赛前的一秒还在讨论修改着自己的材料的那些日子,忙碌却鲜活,焦躁却开心,令人不舍。对于最终的结果,总归有些许不甘,但压倒性的是对团队的骄傲和卸下一件事的开心。
半年多的时间里,我学会了主动探寻法律争议和问题解决,学会了在浩瀚的材料里找到一条路,学会了找到自己的节奏。我看到了队友们和教练老师们最美丽最可爱的一面,将许多难忘又动人的瞬间都封印在脑海里。我们很幸运,老师和教练都专业又可爱,他们像我们的主心骨一样,抓牢着我们,能在一次又一次的训练中一针见血地提出灵魂拷问,也会和我们一起吸奶茶吃火锅不亦乐乎。
学海无涯,不说再见!
王宸宇:
参加Jessup最大的感受是Best Team Ever! 一开始的时候什么都不会,包括找材料找case,靓仔和仇老师给了很多方向上的建议,和队友们互相交流着才算是勉强入了门。而后就是漫长的写文书改文书写文书改文书写文书改文书写文书改文书,仇老师给改了四轮稿子,万哥和Ava跟我交流论点的构建,子晗学姐帮忙最后校对改表达……ddl前的那个通宵至今想来还是紧张到冒汗。再然后就是几乎日日接受潘潘的灵魂逼问,不断修正论点,练习Oral的表达,回应,内容,结构,同时也还在不断地暴风吸入新内容新论据,对事实不断地琢磨,正赛开始后研究对手的memo……健慧和子珊的R方的稳定发挥和子晗每次的无敌开头,都让我一遍又一遍地安心,可以毫无后顾之忧地尽力做好自己的部分。最后的结果还是有些遗憾,但是这是毫无疑问的Best Team Ever了!
撰稿:陈靓
供图:Jessup参赛队